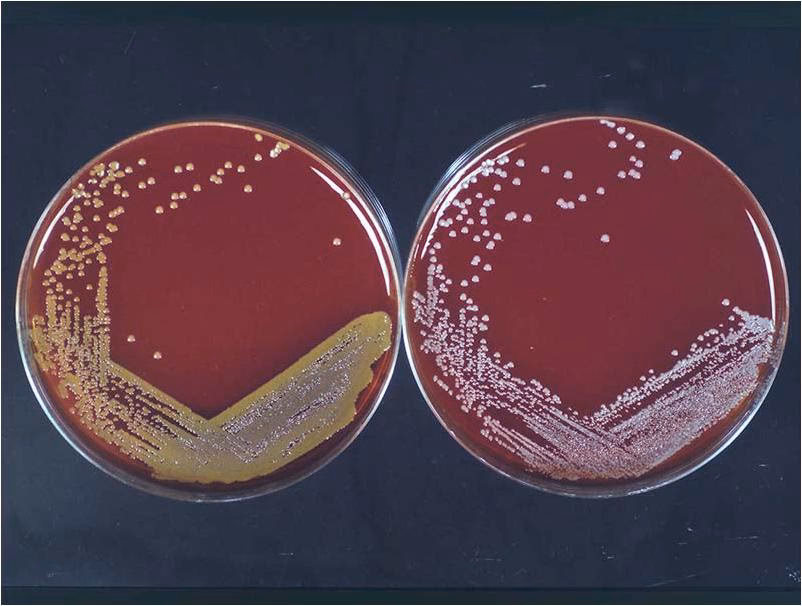

22/01/2022
En el fascinante universo de la alta repostería, a menudo nos encontramos con que la creación de un postre sublime se asemeja más a un experimento científico que a una simple mezcla de ingredientes. La búsqueda del sabor perfecto, de la textura ideal, nos lleva por caminos de precisión y técnica que bien podrían tener lugar en un laboratorio. Hoy vamos a adentrarnos en la 'microbiología del sabor', una metáfora que nos ayudará a entender cómo identificar y potenciar los componentes estrella de nuestras creaciones, tal como un científico aísla un microorganismo. Nuestro objetivo: aislar el Staphylococcus aureus de la pastelería, ese ingrediente dorado y protagonista que puede elevar un pastel de bueno a legendario o, si se maneja mal, arruinarlo por completo.

- El Laboratorio del Sabor: Aislamiento del Ingrediente Estrella
- Pruebas de Fuego: La Verificación Bioquímica de la Perfección
- Más Allá del 'Aureus': Explorando el Universo 'Streptococcus' de la Repostería
- Maestros del Relleno: Los Creadores de Pus... ¡Delicioso!
- Preguntas Frecuentes (FAQ) del Pastelero Científico
El Laboratorio del Sabor: Aislamiento del Ingrediente Estrella
Imaginemos que nuestra cocina es un laboratorio y nuestra masa, una muestra compleja llena de posibilidades. Queremos encontrar ese elemento único, nuestro 'ingrediente aureus', que definirá el carácter de nuestro postre. Para ello, necesitamos un 'medio de cultivo' selectivo que favorezca su desarrollo y nos permita distinguirlo de otros componentes menos relevantes. En nuestro mundo, este medio es el Agar Manitol Salado de la repostería: una base de bizcocho o crema especialmente formulada para resaltar ciertas notas.
Pensemos en una base de bizcocho con un toque de sal y un azúcar específico como el manitol. Al 'sembrar' nuestra mezcla de sabores (extractos, frutas, especias) sobre esta base y hornearla (incubar), observaremos cómo reaccionan. El resultado nos dará dos tipos de 'colonias' o resultados de sabor:
- Colonias Amarillas (Doradas): ¡Eureka! Este es nuestro Staphylococcus aureus. Es el sabor que ha reaccionado perfectamente con nuestra base, fermentando el 'manitol' (el azúcar especial) y creando un perfil de sabor vibrante, complejo y dorado. Puede ser una nota de vainilla que se ha vuelto más profunda, un cítrico que ha alcanzado su punto álgido de acidez y dulzor, o un caramelo perfectamente tostado.
- Colonias Blancas (Níveas): Estos son otros sabores presentes, como el Staphylococcus epidermidis o saprophyticus de nuestra receta. No son malos, pero son más simples, no han interactuado de forma tan espectacular con la base. Pueden ser notas lácteas suaves o un dulzor plano. Son importantes, pero no son la estrella.
Una vez identificada nuestra 'colonia dorada', la aislamos para trabajar con ella en estado puro, potenciándola en el resto de la receta.
Pruebas de Fuego: La Verificación Bioquímica de la Perfección
Tener un gran sabor no es suficiente. En pastelería, la textura es reina. Por eso, sometemos a nuestro 'ingrediente aureus' a dos pruebas cruciales para confirmar su 'patogenicidad', es decir, su capacidad de impactar y transformar positivamente nuestro postre.
La Prueba de la Coagulasa Cremosa
Esta es la prueba definitiva para cualquier crema, flan, mousse o cheesecake. La 'coagulasa' es la enzima de la textura perfecta, la que nos indica si nuestra mezcla cuajará correctamente. Para realizarla, preparamos nuestra crema (nuestro 'plasma') y le añadimos nuestro ingrediente estrella, llevándola a la temperatura de cocción adecuada (nuestros 37°C metafóricos) durante un tiempo controlado.
El resultado se mide por la formación de un 'coágulo', es decir, el grado de firmeza y cremosidad. Un resultado positivo confirma que nuestro ingrediente no solo aporta sabor, sino que contribuye a una estructura celestial.
| Resultado | Descripción Visual | Significado en Pastelería |
|---|---|---|
| Negativo | Líquido, sin cambios. | La crema no ha cuajado. Un desastre. |
| (+) Positivo Débil | Pequeños grumos o coágulo frágil. | Textura aceptable pero mejorable. Mousse aireada. |
| (++) Positivo Medio | Coágulo definido pero tierno. | Textura ideal para un flan tembloroso. |
| (+++) Positivo Fuerte | Coágulo firme que ocupa gran parte del volumen. | Perfecto para una panna cotta que mantiene su forma. |
| (++++) Positivo Total | Toda la mezcla es un coágulo sólido y sedoso. | La textura de un cheesecake horneado impecable. |
Cualquier resultado positivo, por débil que sea, nos indica que nuestro ingrediente es 'patógeno' en el buen sentido: tiene la capacidad de crear una textura inolvidable. Si es 'coagulasa negativo', por muy 'aureus' (dorado y sabroso) que sea, no nos sirve para preparaciones que requieran cuajar.
El Test de la DNasa o la Descomposición Noble
Esta prueba complementaria mide la delicadeza de la estructura, especialmente en bizcochos y masas horneadas. El 'Agar ADN' es nuestra masa base. Tras hornear con nuestro ingrediente, 'añadimos ácido clorhídrico' (que podría ser un sirope o un licor que empapa el bizcocho). Si nuestro ingrediente posee la 'enzima DNasa', habrá 'degradado el ADN' de la masa, es decir, habrá roto las cadenas de gluten de forma controlada, creando una miga increíblemente tierna y húmeda. El resultado es un 'halo transparente' de jugosidad alrededor de cada trozo, en un bizcocho que de otro modo sería más opaco y denso. Es la prueba de una miga que se deshace en la boca.
Más Allá del 'Aureus': Explorando el Universo 'Streptococcus' de la Repostería
No todo en la pastelería es un único protagonista. A veces, la magia reside en la combinación y la sucesión de sabores, como los 'cocos en cadena' de los Streptococcus. Pensemos en una fila de macarons, profiteroles o las capas de un milhojas. Estos postres crecen en un medio diferente, el 'Agar Sangre', que para nosotros será un 'Lienzo de Frutos Rojos', una base de coulis, mermelada o gelatina de color intenso.
Dependiendo de cómo interactúen nuestros sabores en cadena con este lienzo, obtendremos diferentes tipos de 'hemólisis del sabor':
- Alfa Hemólisis: Una destrucción parcial del lienzo. El sabor añadido crea un halo verdoso o de un color diferente alrededor. Imaginemos añadir un toque de menta o albahaca a un coulis de fresa; no lo domina, pero lo transforma, creando un matiz de sabor y color único.
- Beta Hemólisis: Una destrucción total y transparente. El sabor es tan potente y puro que crea un 'halo transparente' de sabor intenso que limpia el paladar. Pensemos en un licor de alta graduación o un extracto puro de almendra amarga que corta la dulzura del fruto rojo y deja una estela limpia y definida.
Maestros del Relleno: Los Creadores de Pus... ¡Delicioso!
En el mundo de la microbiología, existen bacterias llamadas piogenas, capaces de destruir glóbulos blancos y generar pus. En nuestra cocina, esta es una de las metáforas más hermosas y deliciosas. Nuestros 'maestros pasteleros piógenos' son aquellos capaces de crear rellenos tan increíblemente cremosos y fluidos que parecen estallar al primer corte.
Un 'glóbulo blanco' es una estructura rígida en nuestro postre, como una burbuja de aire en una masa o un cristal de azúcar. Nuestros ingredientes 'piógenos' (una yema de huevo, una mantequilla de calidad, un chocolate con alto contenido de cacao) 'matan' estas estructuras, las lisan y las transforman. La muerte de esa estructura rígida da lugar a un 'piocito': una micra de cremosidad perfecta. El conjunto de millones de 'piocitos' forma el 'pus' más deseado del mundo: una crema pastelera sedosa, un ganache brillante o el corazón líquido de un coulant de chocolate. Ser un pastelero 'piógeno' es, por tanto, el mayor de los elogios.
Preguntas Frecuentes (FAQ) del Pastelero Científico
¿Qué diferencia hay entre un postre tipo 'Staphylococcus' y uno 'Streptococcus'?
Un postre 'Staphylococcus' se centra en un único ingrediente estrella, aislado y potenciado sobre una base relativamente neutra. Piensa en un bizcocho de limón perfecto. Un postre 'Streptococcus' se basa en la interacción de múltiples sabores en secuencia o en capas, como un trifle o un postre que juega con diferentes texturas y temperaturas sobre una base vibrante como un coulis.
Mi crema no pasó la 'Prueba de la Coagulasa'. ¿Qué hago?
Un resultado 'coagulasa negativo' significa que tu crema está líquida. Las causas pueden ser una falta de agente gelificante (huevo, gelatina), una temperatura de cocción incorrecta o un ingrediente ácido que ha cortado la mezcla. Deberás revisar la formulación, quizás añadir un poco más de yema o maicena, y controlar la temperatura con un termómetro.
¿Es la 'hemólisis beta' siempre mejor que la 'alfa'?
No necesariamente. Depende del efecto que busques. La 'beta hemólisis' (sabor puro y limpio) es ideal para un postre minimalista y elegante. La 'alfa hemólisis' (matiz, complejidad) es fantástica para creaciones más rústicas, sorprendentes y con múltiples capas de sabor.
¿Cómo puedo volverme más 'piógeno' en mis rellenos?
La clave está en la emulsión y la calidad de las grasas. Utiliza ingredientes a la temperatura correcta, bate lo justo y necesario para integrar sin incorporar demasiado aire, y no escatimes en la calidad de la mantequilla, la nata o el chocolate. La paciencia y la técnica son las mejores armas para 'generar pus' delicioso.
Si quieres conocer otros artículos parecidos a Pastelería Molecular: El Arte de Aislar el Sabor puedes visitar la categoría Técnicas.